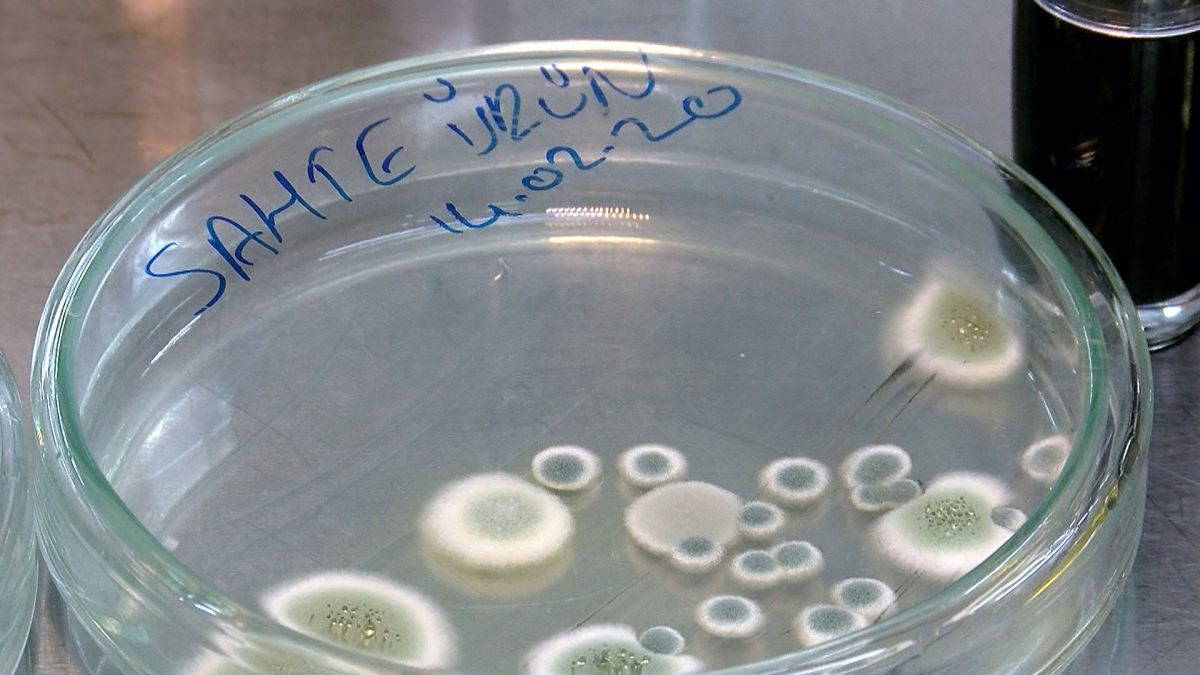

Milyon dolarlık bir piyasa hacmine sahip kozmetik ürünlerde sahteciler para kazanmak için akıl almaz yöntemler kullanıyor. Kozmetik için uygun olmayan ucuz ham maddeleri kullanan sahteciler sınır tanımıyor. Duvar boyasında, ayakkabı boyasında kullanılan pigmentleri maskara üretimi için kullanan, pudralara yemeklik un katan, nemlendiricilerde, bronzlaştırıcılarda kullanılan özel yağlar yerine kızartma yağı kullananlar sahteciler vatandaşların sağlığını tehlikeye atıyor.
MASKARA İÇİN AYAKKABI BOYASI
Kozmetik ürün üretici İbrahim Zengin sahtecilerin ucuz ham madde ve yüksek kar elde etmek için bu tür yöntemlere başvurduklarını belirterek, “Yapılan sahtecilikler çok çeşitli. Önce ucuz hammaddeden başlıyor. Makyaj malzemelerinde kullanılan her pigment kozmetik için uygun değildir. Ayakkabı boyası için kullanılan pigment endüstriyel bir pigmenttir. Kozmetiğe uygun değildir. Arada büyük bir fiyat farkı vardır. Ancak sahte ürün üretenler endüstriyel boyaları her türlü malzemede kullanabilirler. Sahte ürün üretenler 50 euroya alınan bir pigmenti 1 dolara alıyorlar. 1 dolarlık bir pigmentle ayakkabı boyası, duvar boyası üretebilirsiniz ama rimel olarak, makyaj malzemesi olarak üretemezsiniz. Renk verir ancak sağlık için uygun değildir" diye konuştu.
“GÜZELLİK SAĞLIĞIN ÖNÜNE GEÇMEMELİ"
Özellikle internet üzerinden satışların sahtecileri artırdığını söyleyen Zengin, “Pudranın içine un koyuyorlar. Talk pudrasına çok benzer özellikte un. Ancak talk pudrası suyu emer, un emmiyor. Bu yüzden yüzünüzde hamur elde etmiş oluyorsunuz. Bu tür sahtecilikler çok yaygın. Satış kanallarının çeşitlenmesi, online satışların artmasıyla birlikte çoğaldı. Denetimi ise zorlaştı. Güzellik önemli ama sağlığın önüne geçmemeli. Sahte bir maskara kullandığınız zaman mutlaka doktor ihtiyacı yaşayacaksınız. İlaç almak zorunda kalacaksınız" dedi.

BULAŞICI HASTALIĞA DİKKAT
Uygun koşullarda üretim yapılmazsa kozmetik ürünlerden bulaşıcı hastalıların hızla yayılabileceği uyarısında bulunan Zengin, “Üretim alanı uygunluğu çok önemli. Burada birtakım kıstaslar var. Haşere ile mücadele, çalışanların sağlık kontrolleri gibi. Çalışanınızda bir hastalık bulunabilir bu da doğal olarak ürüne geçebilir. Özellikle şu sıralar gündemde olan Coronavirüsü hatta kuş gribi, domuz gribi gibi hastalıklar kontaminasyona yani bulaşıcılığa çok açık. Üretilen kozmetik ürünler bulaşıcılığa çok açık ürünler. İnsanlar bunları ellerine, yüzlerine, dudaklarına sürüyorlar. Üretim alanının bulaşıcılığından etkilenebilirler" uyarısında bulundu.

AYIRT ETMEK NEREDEYSE İMKANSIZ
Sahte ürünlerin vatandaşlar tarafından ayırt etmenin kolay olmadığını belirten İbrahim Zengin, vatandaşlara kozmetik ürünleri güvenilir yerlerden alınması tavsiyesinde bulundu. Zengin, “ Bunun önüne geçmek için denetimlerin sıklaştırılması lazım. Kozmetik ciddi bir iş. Bir çok dermatoloğun, kimya mühendislerinin bir araya gelerek meydana getirdiği bir ürün. Derini üst tabakasına uygulanıyor ancak deriden vücudumuza da nüfus eden bir ürün. Kullanılan malzeme, üretim ortamı çok önem kazanıyor. Belli başlı ürünler ve marklar tercih edilmeli. Üretim yeri belli olan bir ürünü şikayet edebilirsiniz. İnternet üzerinden alışveriş yaparken çok daha dikkatli olunmalıdır. Bir ürün doğru yapılmadıysa, kokusu ilk ele verecek etkendir" dedi.